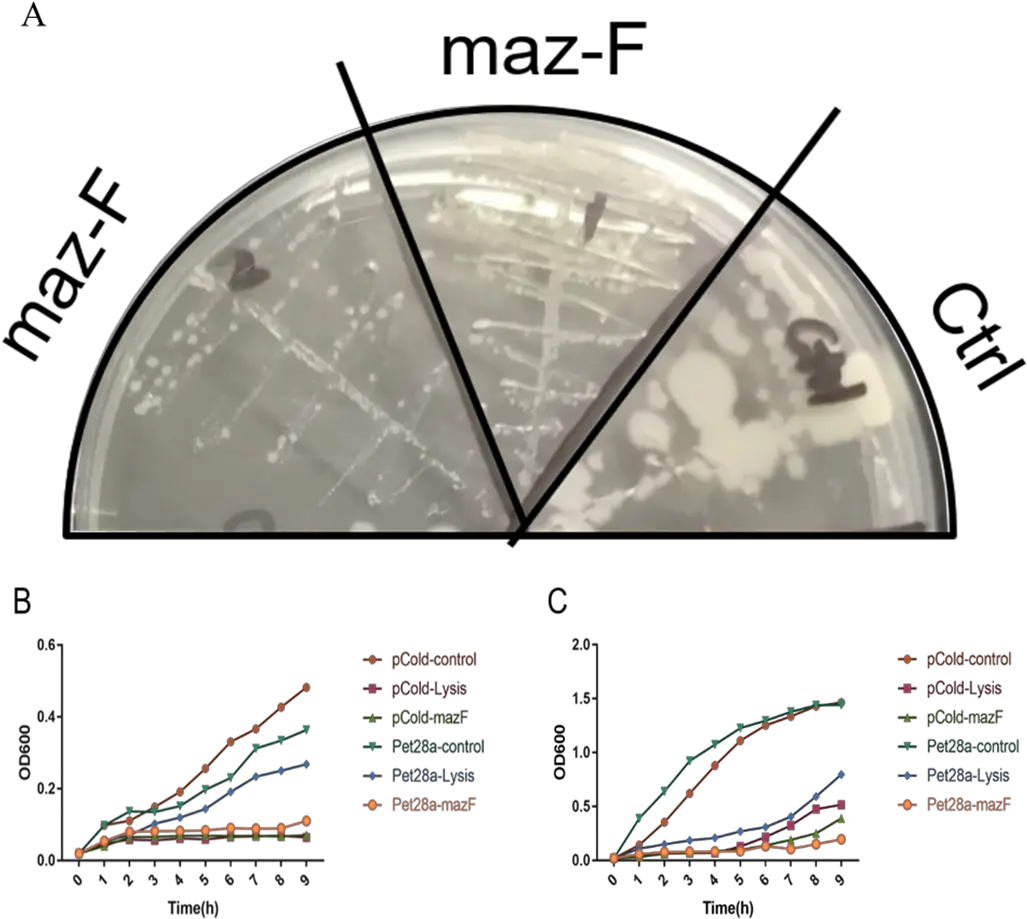

Protractor Png PNG Images - Free Transparent Protractor Png Download
Welcome to our collection of free Protractor Png PNG images with transparent backgrounds. All Protractor Png clipart images are high-quality, royalty-free, and perfect for personal and commercial projects.
Browse through 292 Protractor Png images available for instant download. Click any image to preview, then use the Download button to get the full-resolution PNG file.

Page 3 of 15 (292 total images)
Protractor Png PNG Images - High Quality Transparent Graphics
Our Protractor Png PNG collection offers the highest quality transparent images perfect for your design projects. Each Protractor Png clipart is carefully selected and optimized for various uses including:
- Graphic Design: Use Protractor Png images in your posters, flyers, and marketing materials
- Web Design: Add Protractor Png graphics to websites and applications
- Social Media: Share Protractor Png clipart on Facebook, Instagram, WhatsApp, and more
- Presentations: Enhance PowerPoint and Keynote slides with Protractor Png images
- Personal Projects: Free to use for invitations, cards, and creative works
All Protractor Png PNG files come with transparent backgrounds, making them easy to overlay on any design. Download now and start creating!